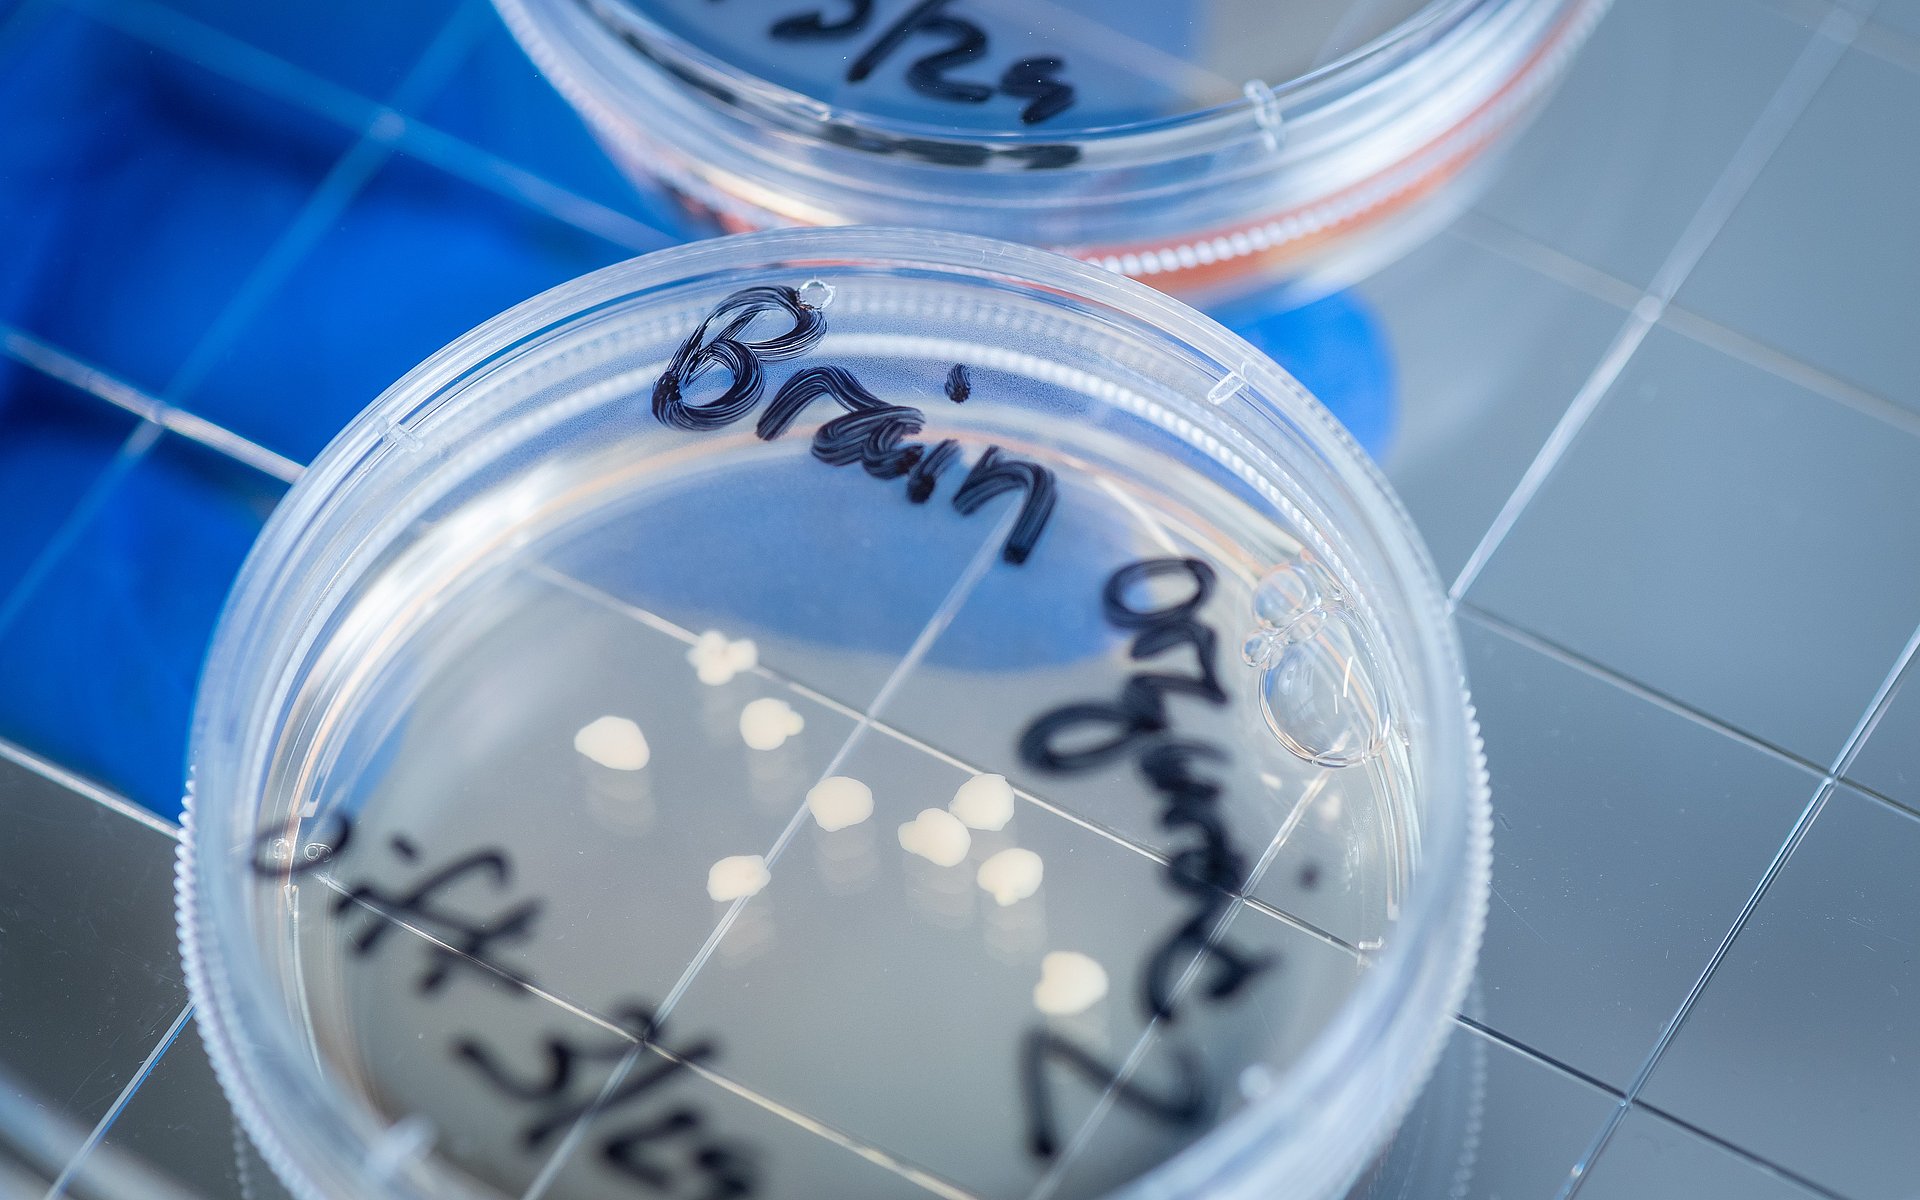
Gehirn-Organoide in einer Petrischale

Neuer Blick auf Immunsystem des Gehirns
Autismus verstehen durch Organoide
Im Gehirn sorgen Mikroglia unter anderem dafür, dass beschädigte Nervenzellen zerstört und ihre Überreste abgebaut werden. Sie können aber auch das Wachstum von Neuronen fördern. Dadurch spielen sie eine wichtige Rolle für die Entstehung des Gehirns, jedoch auch für Erkrankungen des Nervensystems.
Vieles über die Funktionsweise von Mikroglia ist bislang unbekannt. Ein Grund dafür ist, dass sie sich unter Laborbedingungen grundsätzlich anders verhalten als im menschlichen Körper. Ein internationales Forschungsteam, an dem Simon Schäfer, Professor für Advanced Organoid Technologies for Mental Health Research an der Technischen Universität München (TUM), maßgeblich beteiligt war, schildert im Fachmagazin „Cell“ einen Lösungsansatz für dieses Problem.
Mikroglia und Organoid aus Stammzellen
„Außerhalb des Gehirns verlieren Mikroglia fast jede Funktion”, sagt Prof. Rusty Gage, Letztautor der Studie vom kalifornischen Salk Institute. „Wir bilden deshalb die Umgebung des Gehirns in einem Organoid nach, um menschliche Mikroglia zu studieren. So erhalten wir ein Instrument, um zu untersuchen, wie das gesunde und das kranke Gehirn die Mikroglia beeinflussen – und umgekehrt, wie gesunde und kranke Mikroglia das Gehirn beeinflussen.“
Das Team entwickelte zum einen ein Verfahren, um Mikroglia aus menschlichen pluripotenten Stammzellen herzustellen. Zum anderen gelang es den Forschenden, ebenfalls aus Stammzellen ein etwa fünf Millimeter großes Organoid herzustellen. Anders als mit bisherigen Gehirn-Organoiden lässt sich mit diesem nicht nur die frühe Entwicklungsphase des Hirns nachstellen, sondern auch spätere Stadien. Das ist eine wichtige Voraussetzung für das Studium von Erkrankungen, die erst im späteren Verlauf des Lebens auftreten.
Ein 3D-Zellsystem
„Organoide werden oft als eine Art Mini-Version eines Organs beschrieben“, sagt Simon Schäfer. „Das weckt in diesem Fall aber falsche Assoziationen. Das Gehirn verbindet man mit Bewusstsein, mit Empfindungen und Denken. Dazu können unsere Organoide nie in der Lage sein - und sollen es auch nicht.“ Zwar beinhalten die Organoide Nervenzellen, die auch untereinander kommunizieren, erläutert Schäfer. Es fehlen jedoch die Vernetzungen verschiedener Bereiche, die Denken und Bewusstsein erst ermöglichen. „Nüchterner betrachtet kann man von dreidimensionalen Zellsystemen sprechen, mit denen wir einzelne Aspekte der Hirnentwicklung nachstellen“, sagt Schäfer.
Prozesse im Körper nachgeahmt
Als nächsten Schritt entwickelte das Team ein Verfahren, um die gezüchteten Mikroglia in Organoide einzupflanzen. Damit stellen die Wissenschaftler:innen einen weiteren Prozess in der Entstehung unseres Gehirns nach: Mikroglia wandern erst ungefähr ab der fünften Schwangerschaftswoche in den Bereich, der später zum Gehirn wird.
Bislang entspricht das Verhalten der Mikroglia allerdings auch in Organoiden in der Kulturschale nicht dem im menschlichen Körper. Das Team konnte die Organoide jedoch in den Körper von Mäusen einsetzen. In einem lebenden Organismus verhielten die Mikroglia sich wie ihre Pendants im Gehirn. Sie vermehrten sich und konnten beschädigte Neuronen des Organoids beseitigen. „Wir arbeiten jetzt daran, herauszufinden, wie wir unsere Organoide auch in der Kulturschale dazu bringen, sich wie im Körper zu verhalten“, sagt Simon Schäfer.
Organoide aus Zellen von autistischen Patient:innen
Mit den neuen Organoidsystemen wollen die Forschenden einerseits neue Erkenntnisse über die Entstehung des Gehirns gewinnen. Andererseits können sie helfen, individuelle Erkrankungen besser zu verstehen: Aus Hautzellen von drei Patient:innen mit Makrozephalie-Autismus erzeugten die Wissenschaftler:innen Stammzellen und aus diesen wiederum jeweils Organoide und Mikroglia-Zellen. Vorangegangene Studien hatten ergeben, dass sich bei dieser Autismus-Spektrum-Störung Neuronen und Mikroglia ungewöhnlich verhalten. Jetzt konnte das Team zeigen, dass diese Unterschiede auch in den Organoiden auftraten.
„Unsere Versuche haben gezeigt, dass Mikroglia in Organoiden aus Stammzellen von Patient:innen aggressiver auf beschädigte Zellen reagieren als in Organoiden aus Zellen von Personen aus der Kontrollgruppe“, sagt Simon Schäfer. Die aggressive Reaktion trat auch auf, wenn Mikroglia aus den Stammzellen der Kontrollgruppe in Gehirn-Organoiden von Patient:innen eingebracht wurden. Dementsprechend ergebe sich das Verhalten offenbar eher durch das Umfeld der Mikroglia als durch ihre eigenen Eigenschaften. Das könne eine Erklärung für den Ursprung der Entzündungsprozesse im Gehirn sein, die bei dieser Erkrankung häufig auftreten.
Gehirn, Herz und Bauchspeicheldrüse als Organoid
Simon Schäfer forscht seit 2022 an der TUM. Seine Arbeitsgruppe wird sich insbesondere in die interdisziplinäre Forschung am Center for Organoid Systems einbringen. Die Forschung zu Gehirn-Organoiden ist eines der drei Kernthemen des neuen Zentrums. In den vergangenen Monaten haben andere Teams der TUM bereits vielbeachtete Forschungsergebnisse zu Bauchspeicheldrüsen- und Herzorganoiden vorgestellt.
„An der TUM werden wir das Gehirn-Modell weiterentwickeln, um neue Zusammenhänge zwischen Gehirn und Immunsystem zu finden“, sagt Simon Schäfer. „Darüber hinaus wollen wir aus den stammzell-induzierten Gliazellen Ansätze entwickeln, um bei Hirnschädigungen das betroffene Gewebe reparieren oder ersetzen zu können.“
Schafer, S.T., Mansour, A. A., Schlachetzki, J.C.M., Pena, M., Ghassemzadeh, S., Mitchell, L., Mar, A., Quang, D., Stumpf, S., Santisteban Ortiz, I., Lana, A.J., Baek, C., Zaghal, R., Glass, C.K., Nimmerjahn, A., Gage, F.R. „An in vivo neuroimmune organoid model to study human microglia phenotypes“. Cell, Vol. 186 (2023): DOI: 10.1016/j.cell.2023.04.022.
- Simon Schäfer ist seit 2022 Professor an der TUM. Zuvor forschte er als Mitarbeiter von Prof. Rusty Gage am Salk Institute for Biological Studies in La Jolla, Kalifornien. Ein wesentlicher Teil der Forschung zu diesem Projekt fand dort statt.
- Prof. Schäfer ist Mitglied von SyNergy. Dieser Exzellenzcluster untersucht, auf welche Weise komplexe neurologische Erkrankungen wie Multiple Sklerose oder Alzheimer entstehen. Mit der Systemneurologie als neuen interdisziplinären Ansatz können die Forschenden die vielen beteiligten Prozesse bei neurodegenerativen, neuroimmunologischen und neurovaskulären Krankheiten abbilden.
- Die Professur für Advanced Organoid Technologies for Mental Health Research wurde gefördert über die Hightech Agenda Bayern (HTA).
Technische Universität München
Corporate Communications Center
- Paul Hellmich
- paul.hellmich@tum.de
- presse@tum.de
- Teamwebsite
Kontakte zum Artikel:
Prof. Dr. Simon T. Schäfer
Technische Universität München
Klinikum rechts der Isar
Klinik für Psychiatrie und Psychotherapie
Professur für Advanced Organoid Technologies for Mental Health Research
Tel: +49 89 4140 6661
simon.schafer@tum.de








